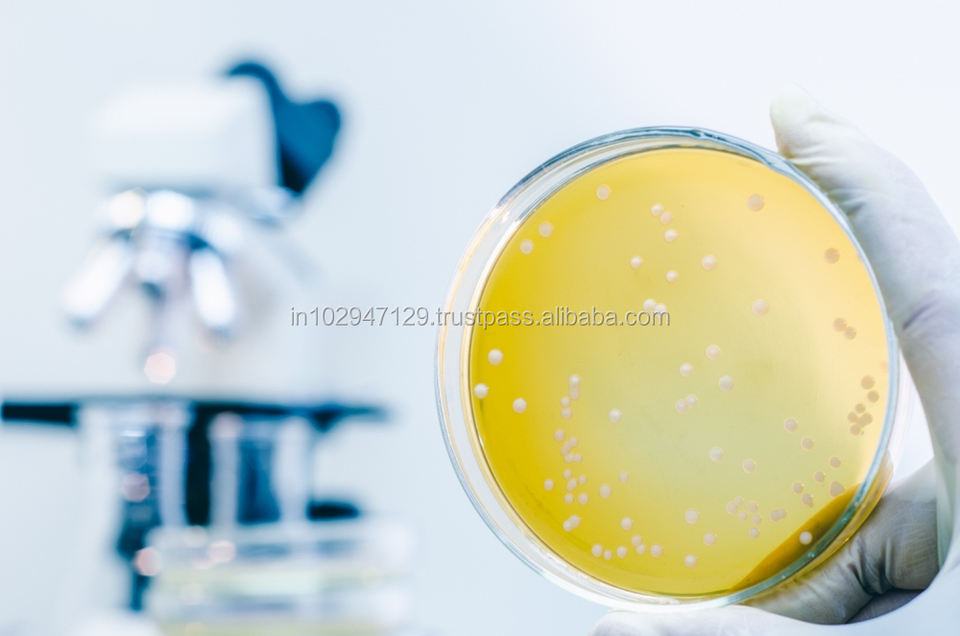

Attributs
BFOG-1Numéro de Type
Maharashtra, IndiaPoint d'origine
Bioclean FOGMarque nom
Environnement amicalCaractéristique
2 annéesDurée de conservation
Forme de poudre mciroencapsuléeApparence
Couleur:Blanc cassé

Chaque paiement que vous effectuez sur Alibaba.com est sécurisé par un cryptage SSL strict et des protocoles de protection des données PCI DSS.

Demandez un remboursement si votre commande n'est pas expédiée, est introuvable ou arrive avec des problèmes liés au produit